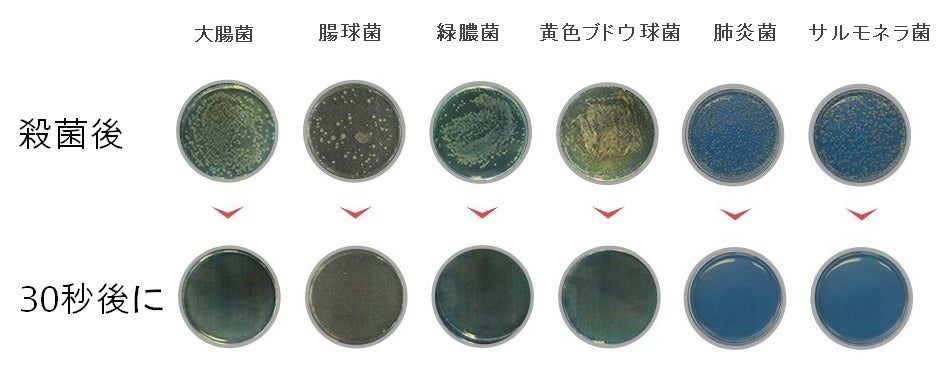

安心できるオゾン除菌水生成器 EraClean mini
3分で99.9%除菌!(※注)
かけるだけで日常が変わります。水だけで除菌効果!
※本製品はすべての菌・ウィルスに効果あるわけではありません。ご検討の方は本文記載内容をご覧いただき、不明点があればご連絡ください。
[韓国のウィルス研究機関である国立建国大学校Kr Biotechでコロナウィルス(COVID19)での検査を行い、特定の条件下で99.99%不活化したことが確かめられました]
EraClean miniオゾン水器は世界最小miniサイズで携帯性に優れ、電気分解された「水」であるため、人体に無害で除菌に有効なオゾン水を生成します。
.EraClean miniオゾン水器は水道水だけで除菌消臭まで日常をより安全にお守りします。

これからはいつどこでも我慢しないで防疫しましょう!私を守るスマートな生活防疫習慣!

食品添加物として認められており、残留可能性も低いため、包丁、まな板、野菜等の食品の洗浄にも使用できます。(ナイフ、まな板、野菜を除菌する場合、30秒後に水で洗浄し使用してください)
新型コロナウィルスのせいで私たちは安全でない世の中に住んでいます。
毎日出勤し、仕方なく一緒に使用しないといけない公共施設で
知らないうちに汚染された物に触れ、細菌の汚染にさらされています。
そういう衛生が心配になる皆様に EraClean miniオゾン水器を紹介します。

いつでもどこでも迅速かつ簡単にできる衛生対策!

コンパクトなサイズでいつどこでも水さえあればOK
(※注)EraClean miniで生成された「オゾン水」は一般的な除菌以外に除菌強化剤(次亜塩素酸水活性剤)4滴を混ぜて使用することを想定しています。この除菌強化溶液剤は食品添加物として認められ、安全に使用できます。どこでも早く簡単な除菌アイテムです!
ウルトラナノバブルでより微細で強力に。
EraClean miniのシステムはオゾン水をミストする過程で「ウルトラナノバブル」を同時に生成します。
オゾン水は、1時間ほども置いておくと、通常の「水」に戻るので、使用直前に作成することを推奨します。
ウルトラナノバブルは直径0.05mmから0.001mm以下の超微細気泡の数を意味し、0.001mm以下の気泡をウルトラナノバブルと言います。O³ミストは最低0.0001mmのナノ気泡で、1cc当たり5億~10億個の最高級微細気泡が含有されています

手をきれいにすることは必須!
一般的なアルコール消毒はたくさん使用する場合、乾燥したり繰り返して使用する場合、手があれる現象が起きます。

一般的な除菌をしたい時は水道水だけでできます。水を入れた後、スイッチをつけると3分後強力なオゾン水を生成します。

EraClean miniの一番の特徴。それは何と言っても必要な材料は「水」だけということ!
いつどこでも使い方は非常に簡単です。容器に水を入れ、本体下段のスイッチを触ると青く光ります。電極から泡が発生し、たった3分で完了。2段階(青)で電気分解方式により「オゾン水」を生成します。
水さえあればいつどこでも安全に!オゾン水
本来「オゾン」はその名通り酸素同位元素であるオゾンが溶けた水のことで、オゾンは酸化する力があり、除菌、有機物分解作用があり、強力な除菌性能が認められています。
オゾンによる除菌は薬剤による除菌と違って「耐性菌」が作られません。

これからは除菌/消臭が必要な瞬間、我慢しないで安全にケアしましょう!
携帯性が優れるため、使用する時、場所を選びません。
毎日外で使うマスクにもかけるだけで除菌!(かけた後、マスクが乾燥する使ってください)

一番よく使う携帯電話やパソコン、事務用品!
非衛生的なベタッとする触感のスマートフォンにもOK.(30秒後に拭いて使用してください)

家の中でも衛生が心配になるテーブルやキッチンでも取っ手にも使用することができます


毎日着て持って歩く服とかばん、そしてハンドバック! 外出後、細菌がつく製品です
かけるだけできれいに管理できます。

全ての匂いを消臭する消臭作用!
オゾンは消臭作用でトイレや生ごみ、タバコなどの匂いの原因となるアンモニアを減少させることも明らかになっています。
細菌が最も多いトイレ!もしオフィス、カフェ等のトイレならなおさら必要です。

無害な除菌剤を作るためにオゾン水除菌器!
これまでオゾン水を作る方法は気体を注入する「ガス溶解法」が一般的で、機械も大型になるしかなく、一般人は使用できませんでした。
「オゾン」は1985年頃から実用化された技術であり、人体に無害で、製造時の低い運営コストで注目を浴びました。実際、食品の洗浄、消毒等に導入するヨーロッパやアメリカ、日本では食品添加物として認められており、子どものおもちゃ、食品加工工場、ホテル、レストラン、病院等の様々な現場で使われています。
EraCleanは超小型電極開発と「電気分解法」を活用した携帯用ウィルス除菌剤を作るための努力の末、日常生活で携帯性の優れたオゾン水発生器を作り、新型コロナウィルス発生後5カ月の研究の末、EraCleanのオゾン水とウィルス死滅活性剤を利用することで特定の環境下(※)で新型コロナウィルス99.99%不活化できることが確認されました。
(※)検査環境下となります。
(※)細菌、コロナ19ウイルス殺菌試験成績書

韓国のウィルス研究機関である国立建国大学校Kr Biotechで認証を受けた信頼できる製品です。


① スプレーヘッド
② EraClean mini 本体
③ 充電用Cタイプのケーブル
④ 除菌剤3個セット(10ml / 50回X3)150回使用可能.
-本体定価 16,500円 (製品の価格に消費税が含まれています)
・10,725円:超お得割引 EraClean mini 1個35%割引/除菌剤3本を含む(限定販売:100名)
・11,550円:CAMPFIRE割引 EraClean mini 1個30%割引/除菌剤3本を含む(限定販売:5000名)
・ 51,150円:超お得家族割引 EraClean mini 5個 38%割引/除菌剤15本を含む(限定販売:100名)
・ 954,000円 : CAMPFIRE団体割引 EraClean mini 10個 40%割引/除菌剤30本を含む(限定販売:50 名)
- 付属品のみのリターン -
・ 6,000円: CAMPFIRE割引除菌剤セット X 2
EraClean miniを購入される方は除菌剤を追加購入することができます。除菌剤のみ購入することができません。
使用上の注意
「EraClean mini」は電極に電気を流し、ケース内部の水(蒸留水または水道水、飲用水)をオゾン水に変換する製品です。オゾン水は取り扱いを間違えると人体に影響を及ぼす恐れがあるため、以下の事項をご注意ください。
精製水、水道水、飲用水以外は使用しないでください。
· 防水ではありません。チャージコネクターは濡れないように使用してください。
オゾン特有の匂いが気になる方、使用中に体調の変化を感じた場合は即時使用を中断し、換気してください。
· 子どもに使わせたり本製品で遊ばせないでください。
· 絶対分解したり修理、改造しないでください。火災または誤作動を起こし、怪我させる恐れがあります。
スプレーノズルを分離した状態では作動しないでください。
· 落とすか強い衝撃を与えないでください。故障や損傷の原因となります。
* 温水を本体ケースに入れないでください。変色や変形、故障の原因となります。
オゾン水の特性について
「EraClean mini」の勧奨温度は5~20℃です。
· オゾン水生成時、水温によって濃度が変わります。水温が低いほど、オゾン水の濃度はさがります。夏、外の熱気により水温が20℃を越えた場合、オゾン水の濃度が上がらない場合があります。水温が20℃を越える場合、冷蔵庫に保管した蒸留水、水道水、飲用水または凍りで温度を下げた後、ご使用ください。
· オゾン濃度の減少速度は環境によって変わるため、できれば生成後、即時ご使用ください。
· より濃度の強いオゾン水をお求めの方は同封されている専用スプーンで塩(添加物の入ってない一般の塩)を少し入れてご使用ください。
- EraCleanのチャレンジ -
「EraClean mini」は数年に渡り研究・開発した製品です。検証及びテストを繰り返し、ようやく本プロジェクトの開始に至りました。現在、予想できなかった世界的伝染病の蔓延によりヨーロッパやアメリカにも輸出契約を進めております。そんな中、日本国内ではクラウドファンディングで初めて公開することになりました。


Q) 交換・修理の方法について
A) A/S 受付方法 : 以下メールまで具体的な問題の内容と写真(動画)を送ってください。
A/S申し込み時、韓国までの送料はパトロン様のの負担となります。
修理後の日本への送料は自社で 負担いたします。
-製造-
フランコモータ/ブルーテック-(韓国生産・製造製品です)
-販売-
Medi welfare
メール : john103015@gmail.com
ソウル市江南区テヘラン路24道
・韓国生産・製造製品です。
Medi welfare
㈱メディウェルフェアはここ12年間スキンケアヘルスケアの研究をし、様々な製品を発売、公開し、デザインやアイデアを備えた製品をソーシングし、合理的な価格と良い品質の製品を提供するために努力し続けています。
最新の活動報告
もっと見るこんにちは。現在、日本の地域物流センターに到着と確認ができます。
2021/01/17 22:52こちらの活動報告は支援者限定の公開です。こんにちは。発送についてご案内いたします。
2020/12/02 14:30こちらの活動報告は支援者限定の公開です。
ウイルス殺菌実験(本文)公開
2020/08/22 17:00안녕하세요 메디 웰 페어입니다.코로나 살균제는 한국에서 코로나 19 바이러스 5 개월의 연구 끝에 개발 된 제품으로 코로나 19 바이러스를 99.99 % 살균되는 인증을 한국에서 받고 , 프로젝트의 신뢰에 대한 연구 자료 본문 올립니다 .믿고 사용 하셔도 문제는 없습니다드립니다.다른 일반 세균, 대장균, 뻬 료무 균 등의 실험에서는 프로젝트 의 본문에 넣은 사진과 같이 99.9 % 살균 효과가있었습니다. もっと見る





コメント
もっと見る